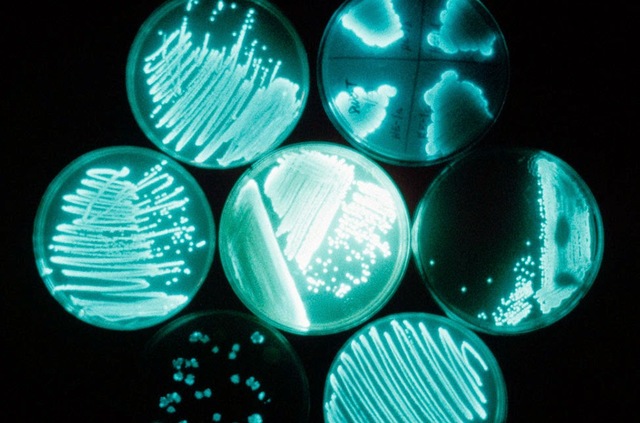
BACTERIAS BIOLUMINISCENTE

-
La ballenas ademas de ser el animal mas grande del mundo, también son las mas ruidosas, estas se comunican para asi poder reunirse y aparearse
-
estos animales marinos ocupan su sonido para poder comunicarse entre ellos, en partículas para atraer a las hembras y así poder aparearse, las señales sonicas pasan a través de las densas moléculas de agua y gracias a esto se disipa de manera muy rápida
-
la hormigas tienen un gran sistema de comunicación en base a una sustancia química que poseen en el cuerpo llamada hidrocarburos
-
La comunicación de las bacterias es en base al intercambio de sustancias químicas que les permiten hacer cosas diferentes, estas liberan moléculas químicas para señalar su presencia a las otras bacterias para formar cuorums, necesitan comunicarse para poder crear tareas que no puede realizar una sola
-
Se comunicas con aromas químicos que excretan para marcar su territorio, estos animales para librarse de principal depredador que era la serpiente de cascabel, masticaban la piel que mudaban estas serpientes para crear una especie de pasta y con ella lamerse lo costados para así poder despistar a la serpiente con su mismo aroma
-
Este animal ocupa la comunicacional vocal para comunicarse este sonido puede alcanzar los 10 km de distancia e indicar su posición al resto de la manada de lobos,
-
Los chimpancés se comunican de una forma similar a los humanos, estos ocupan sonidos lo que nosotros llamamos vocalizaciones, también emplean gestos
Want to make a timeline like this?
Use Timetoast to turn dates, events, milestones, and phases into a clear visual timeline you can build and share. Timetoast is a timeline maker for work, school, research, and stories.